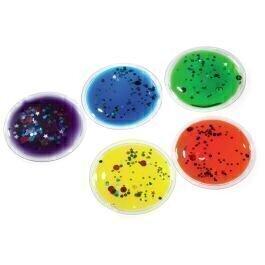

Ce produit est extrait d'une liste de cadeaux (Anniversaire, Noël, ...) déposée sur Kadolog. Kadolog permet de créer des listes de cadeaux (Anniversaire, Noël, ...)
en toute liberté. Il est possible d'ajouter toutes vos envies cadeaux et de recevoir les dons directement sur votre compte. Avec les dons reçus, vous êtes alors libre d'aller acheter vos produits (comme ce 'CERCLES PAILLETÉS
') où et quand vous le souhaitez.